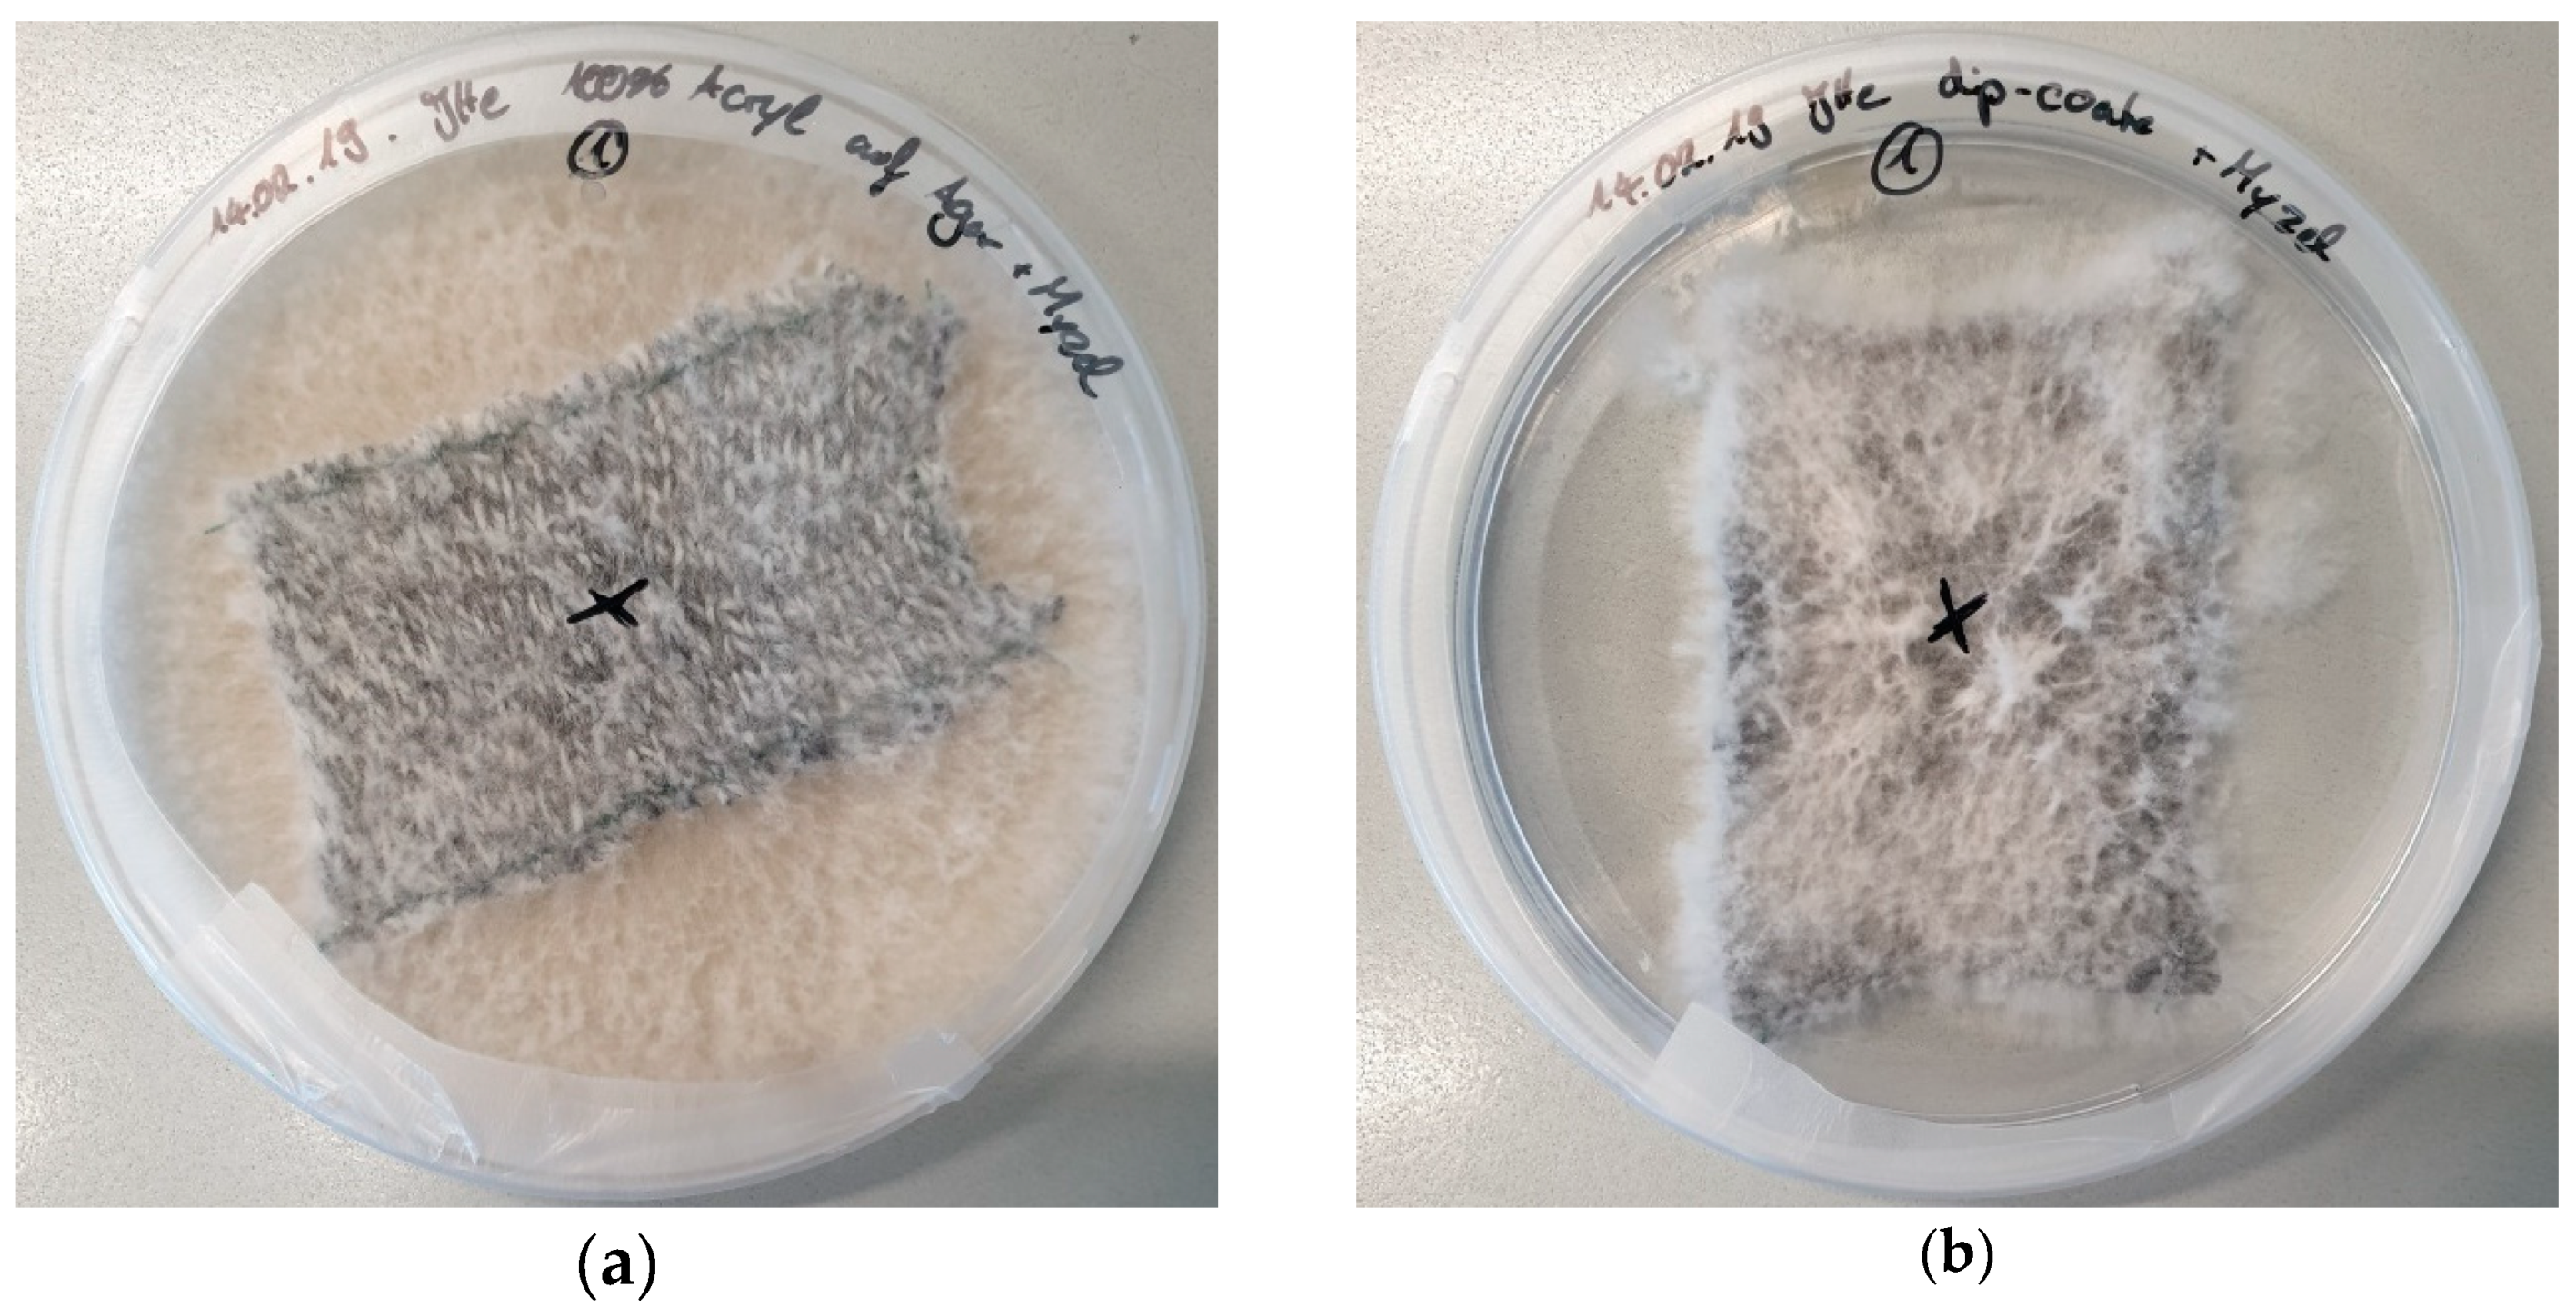
Materials 12 02270 g003a
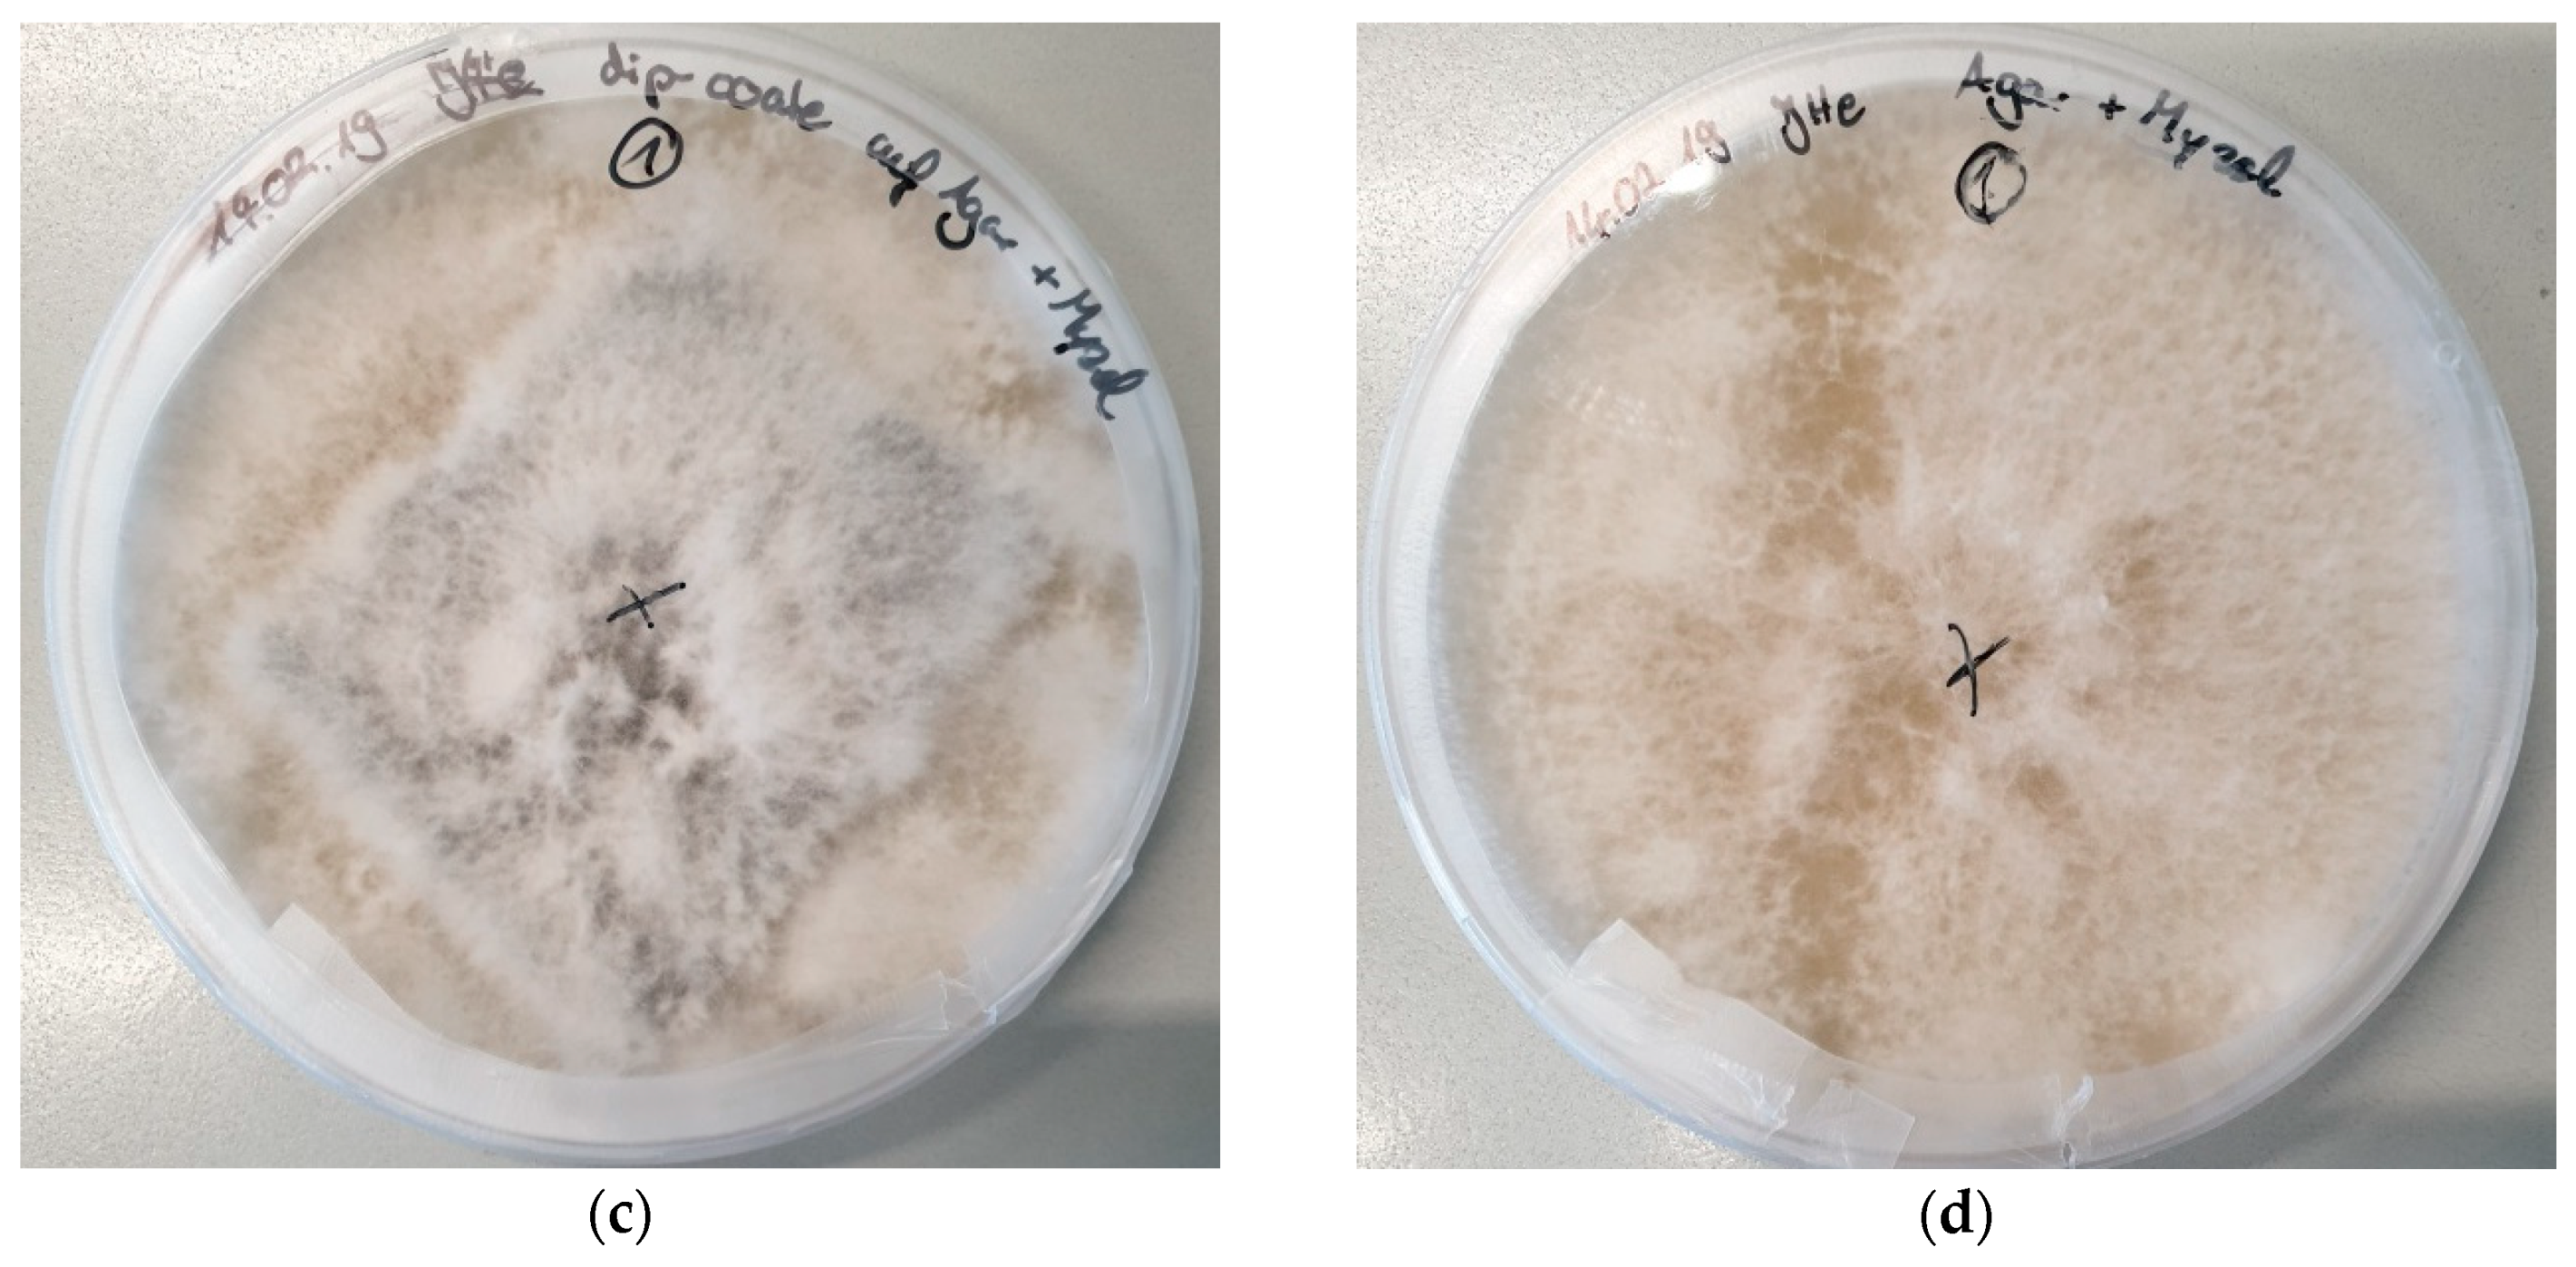
Materials 12 02270 g003b
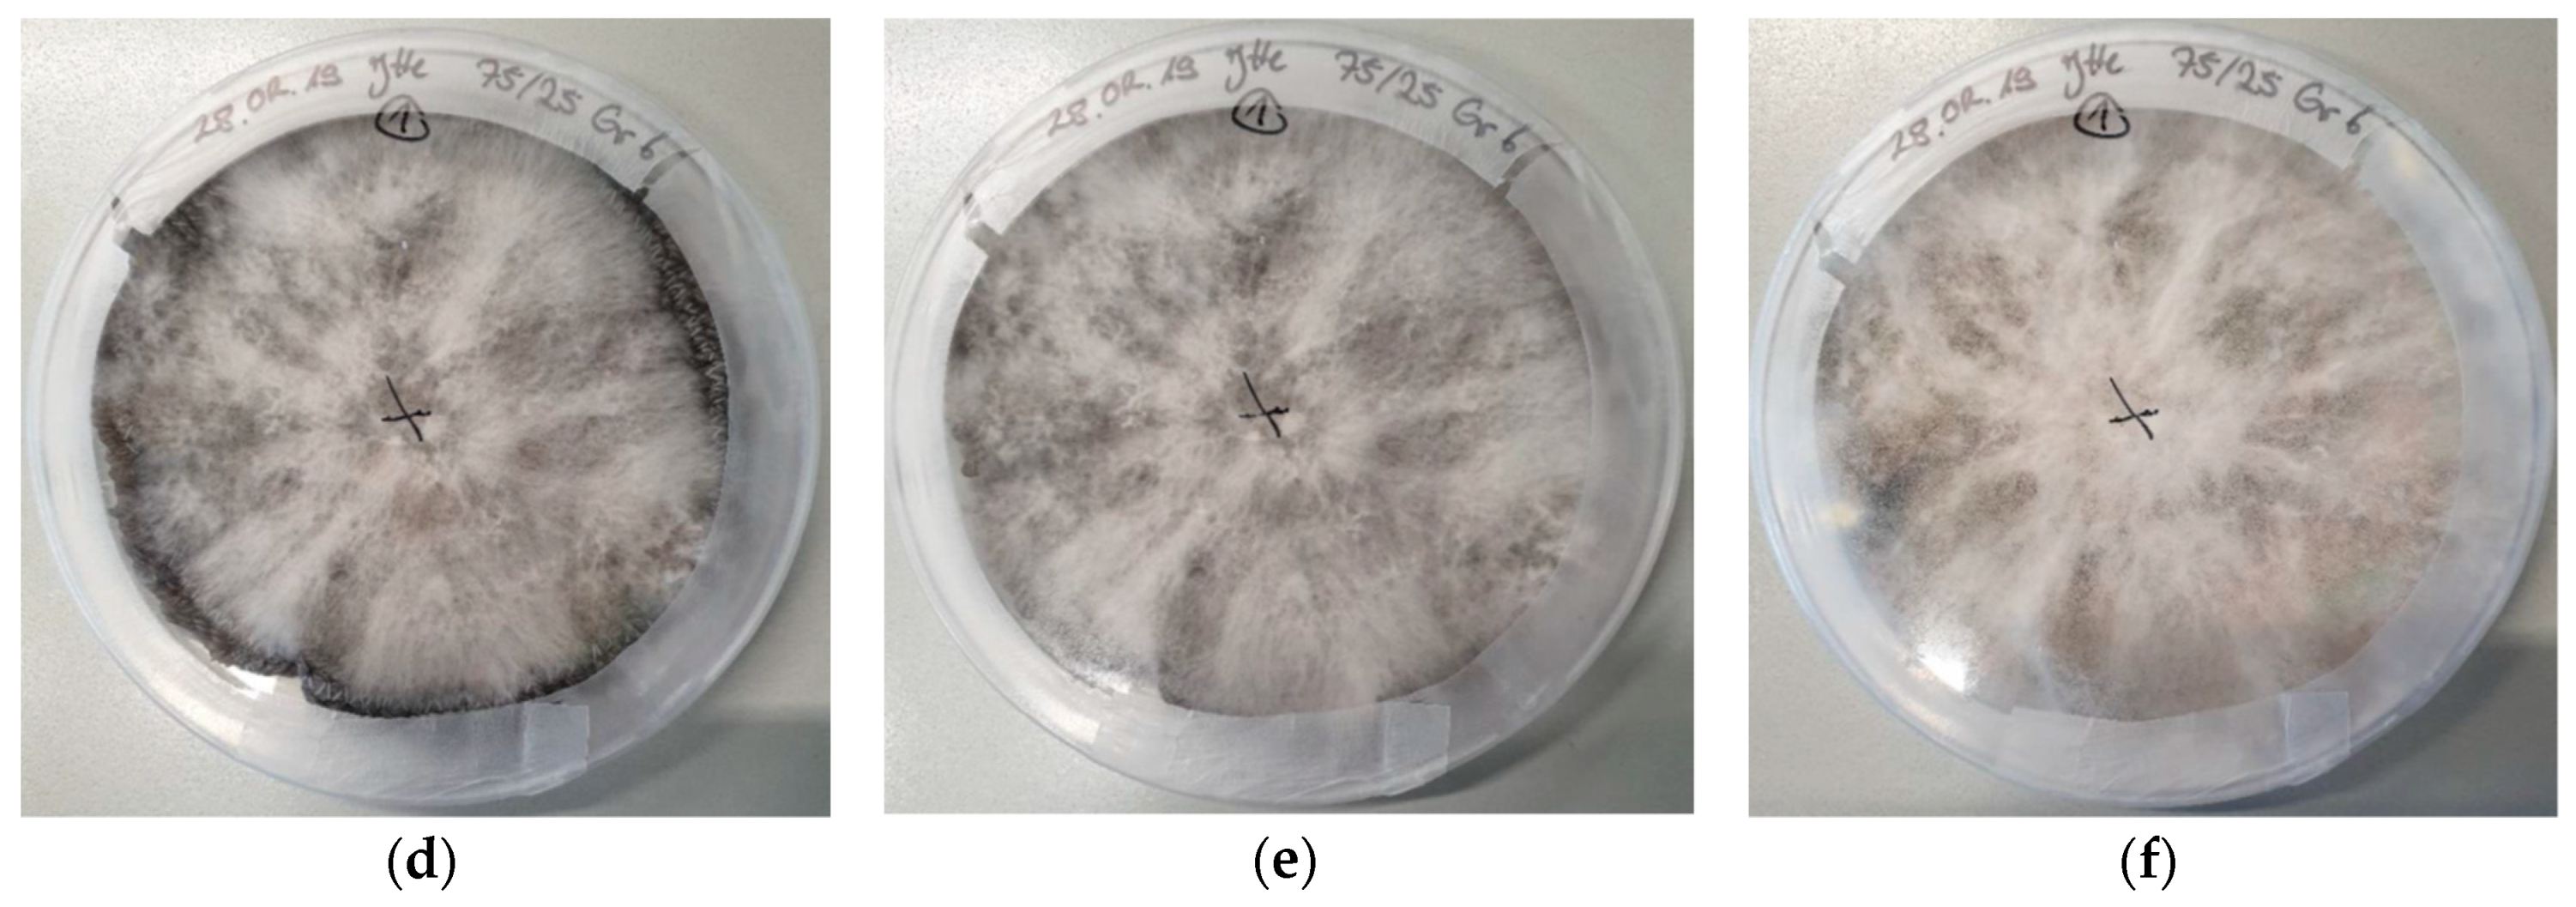
Materials 12 02270 g004b

Growth of Pleurotus Ostreatus on Different Textile Materials for Vertical Farming
Abstract
:1. Introduction
2. Materials and Methods
3. Results and Discussion
4. Conclusions
Author Contributions
Funding
Conflicts of Interest
References
- Govedarica-Lucic, A.; Mojevic, M.; Perkovic, G.; Govedarica, B. Yield and nutritional quality of greenhouse lettuce (Lactuca sativa L.) as affected by genotype and production methods. Genetika 2014, 46, 1027–1036. [Google Scholar] [CrossRef]
- Nikolich, L.; Dzigurski, D.; Ljevnaich-Masich, B.; Cabilovski, R.; Manojlovich, M. Weeds of Lettuce (Lactuca sativa L. subsp. Secalina) in organic agriculture. Bulg. J. Agric. Sci. 2011, 17, 736–743. [Google Scholar]
- Rebarz, K.; Borówczak, F.; Gaj, R.; Frieske, T. Effects of cover type and harvest date on yield, quality and cost-effectiveness of early potato cultivation. Am. J. Potato Res. 2015, 92, 359–366. [Google Scholar] [CrossRef]
- Dan, M.; Visileanu, E.; Dumitrescu, I.; Mocioiu, A.-M.; Radulescu, H.C.; Radulescu, R.; Lagunovschi, V.L. Manufactures textile cover meant for plant protection in the cold season. In Proceedings of the 3rd International Conference on Advanced Materials and Systems, Bucharest, Romania, 16–18 September 2010; pp. 33–38. [Google Scholar]
- Scarlat, R.; Rusu, L.; Pricop, F. Knitted agrotextiles for a sustainable agriculture. Ind. Text. 2017, 68, 332–336. [Google Scholar]
- Ponjican, O.; Bajkin, A.; Dimitrijevic, A.; Mileusnic, Z.; Miodragovic, R. The influence of soil mulching and greenhouse covering material on the temperature distribution in lettuce production. In Proceedings of the 39th International Symposium on Agricultural Engineering, Actual Tasks on Agricultural Engineering, Zagreb, Croatia, 22–25 February 2011; Volume 39, pp. 393–401. [Google Scholar]
- De Simone, S.; Lombardi, F.A.; Paladini, F.; Starace, G.; Sannino, A.; Pollini, M. Development of antibacterial silver treatments on HDPE nets for agriculture. J. Appl. Polym. Sci. 2015, 132, 41623. [Google Scholar] [CrossRef]
- Gogo, E.O.; Saidi, M.; Ochieng, J.M.; Martin, T.; Baird, V.; Ngouajio, M. Microclimate modification and insect pest exclusion using agronet improved pod yield and quality of French bean. HortScience 2014, 49, 1298–1304. [Google Scholar] [CrossRef]
- Martin, T.; Kamal, A.; Gogo, E.; Saidi, M.; Melétré, E.; Bonafos, R.; Simon, S.; Ngouajio, M. Repellent effect of alphacypermethrin-treated netting against Bemisia tabaci (Hemiptera: Aleyrodidae). Hortic. Entomol. 2014, 107, 684–690. [Google Scholar] [CrossRef]
- Mutisya, S.; Saidi, M.; Opiyo, A.; Ngouajio, M.; Marin, T. Synergistic effects of agronet covers and companion cropping on reducing whitefly infestation and improving yield of open field-grown tomatoes. Agronomy 2016, 6, 42. [Google Scholar] [CrossRef]
- Ehrmann, A. On the possible use of textile fabrics for vertical farming. Tekstilec 2019, 62, 34–41. [Google Scholar] [CrossRef]
- Working Paper No. ESA/P/WP/248—World Population Prospects: The 2017 Revision, Key Findings and Advance Tables; United Nations, Department of Economic and Social Affairs, Population Division: Washington, DC, USA, 2007.
- Global Hunger Index [online]. Results—Global, Regional and National Trends. Available online: http://www.globalhungerindex.org/results/ (accessed on 31 December 2018).
- Pinstrup-Anderson, P. Is it time to take vertical indoor farming seriously? Glob. Food Secur. 2018, 17, 233–235. [Google Scholar] [CrossRef]
- Obodai, M.; Ferreira, I.C.F.R.; Fernandes, A.; Barros, L.; Mensah, D.L.N.; Dzomeku, M.; Urben, A.F.; Prempeh, J.; Takli, R.K. Evaluation of the chemical and antioxidant properties of wild and cultivated mushrooms of Ghana. Molecules 2014, 19, 19532–19548. [Google Scholar] [CrossRef] [PubMed]
- Reis, F.S.; Pereira, E.; Barros, L.; Sousa, M.J.; Martins, A.; Ferreira, I.C.F.R. Biomolecule profiles in inedible wild mushrooms with antioxidant value. Molecules 2011, 16, 4328–4338. [Google Scholar] [CrossRef] [PubMed]
- Fogarasi, M.; Socaci, S.A.; Dulf, F.V.; Diaconeasa, Z.M.; Fărcaș, A.C.; Tofană, M.; Semeniuc, C.A. Bioactive Compounds and Volatile Profiles of Five Transylvanian Wild Edible Mushrooms. Molecules 2018, 23, 3272. [Google Scholar] [CrossRef] [PubMed]
- Oliveira, S.F.; da Luz, J.M.R.; Kasuya, M.C.M.; Ladeira, L.O.; Correa Junior, A. Enzymatic extract containing lignin peroxidase immobilized on carbon nanotubes: Potential biocatalyst in dye decolourization. Saudi J. Biol. Sci. 2018, 25, 651–659. [Google Scholar] [CrossRef] [PubMed]
- Parveen, A. Effect of Electrospun Nanofibers on Growth Behavior of Fungal Cells. Ph.D. Thesis, North Carolina A&T State University, Greensboro, CA, USA, 2018. [Google Scholar]
- Sabantina, L.; Kinzel, F.; Hauser, T.; Többer, A.; Klöcker, M.; Döpke, C.; Böttjer, R.; Wehlage, D.; Rattenholl, A.; Ehrmann, A. Comparative study of Pleurotus ostreatus mushroom grown on modified PAN nanofiber mats. Nanomaterials 2019, 9, 475. [Google Scholar] [CrossRef] [PubMed]
- Vieira, F.R.; Nogueira de Andrade, M.C. Optimization of substrate preparation for oyster mushroom (Pleurotus ostreatus) cultivation by studying different raw materials and substrate preparation conditions (composting: Phases I and II). World J. Microbiol. Biotechnol. 2016, 32, 190. [Google Scholar] [CrossRef]
- Parola, S.; Chiodaroli, L.; Orlandi, V.; Vannini, C.; Panno, L. Lentinula edodes and Pleurotus ostreatus: Functional food with antioxidant antimicrobial activity and an important source of Vitamin D and medicinal compounds. Funct. Foods Health Dis. 2017, 7, 773–794. [Google Scholar] [CrossRef]
- Kortei, N.K.; Odamtten, G.T.; Obodai, M.; Wiafe-Kwagyan, M.; Dzomeku, M. Comparative bioconversion of gamma irradiated and steam sterilized “wawa“ sawdust (Triplochiton scleroxylon L.) by mycelia of oyster mushrooms (Pleurotus ostreatus Jadq. Ex. Fr. Kummer). Int. Food Res. J. 2018, 25, 943–950. [Google Scholar]
- Qiu, Z.H.; Wu, X.L.; Gao, W.; Zhang, J.X.; Huang, C.Y. High temperature induced disruption of the cell wall integrity and structure in Pleurotus ostreatusk mycelia. Appl. Microbiol. Biotechnol. 2018, 102, 6627–6636. [Google Scholar] [CrossRef]
- Hoa, H.T.; Wang, C.-L. The Effects of Temperature and Nutritional Conditions on Mycelium Growth of Two Oyster Mushrooms (Pleurotus ostreatus and Pleurotus cystidiosus). Mycobiology 2015, 43, 14–23. [Google Scholar] [CrossRef] [PubMed]
- Melgar, G.Z.; Souza de Assis, F.V.; Coutinho da Rocha, L.; Fanti, S.C.; Duraes Sette, L.; Meleiro Porto, A.L. Growth Curves of Filamentous Fungi for Utilization in Biocatalytic Reduction of Cyclohexanones. Glob. J. Sci. Front. Res. Chem. 2013, 13, 13–19. [Google Scholar]
- Appels, F.V.W.; Camere, S.; Montalti, M.; Karana, E.; Jansen, K.M.B.; Dijksterhuis, J.; Krijgsheld, P.; Wösten, H.A.B. Fabrication factors influencing mechanical, moisture- and water-related properties of mycelium-based composites. Mater. Des. 2019, 161, 64–71. [Google Scholar] [CrossRef]

| Stitch Size | Cotton | Cotton/Linen | Polyacrylonitrile | PAN/Wool |
|---|---|---|---|---|
| 2 | - | - | 1.77 mm | 1.19 mm |
| 4 | - | 2.02 mm | 1.80 mm | 1.16 mm |
| 6 | 2.75 mm | 2.04 mm | 1.84 mm | 1.13 mm |
| 8 | 2.90 mm | 2.06 mm | 1.86 mm | 1.12 mm |
| 10 | 2.98 mm | 2.08 mm | 1.90 mm | 1.05 mm |
| Stitch Size | Cotton | Cotton/Linen | Polyacrylonitrile | PAN/Wool |
|---|---|---|---|---|
| 2 | - | - | 222 g/m2 | 120 g/m2 |
| 4 | - | 553 g/m2 | 200 g/m2 | 114 g/m2 |
| 6 | 701 g/m2 | 496 g/m2 | 192 g/m2 | 107 g/m2 |
| 8 | 660 g/m2 | 430 g/m2 | 170 g/m2 | 93 g/m2 |
| 10 | 560 g/m2 | 378 g/m2 | 148 g/m2 | 79 g/m2 |
| Stitch Size | Cotton | Cotton/Linen | Polyacrylonitrile | PAN/Wool |
|---|---|---|---|---|
| 2 | - | - | 125 kg/m3 | 101 kg/m3 |
| 4 | - | 274 kg/m3 | 111 kg/m3 | 98 kg/m3 |
| 6 | 255 kg/m3 | 243 kg/m3 | 104 kg/m3 | 95 kg/m3 |
| Stitch size 8 | 228 kg/m3 | 209 kg/m3 | 91 kg/m3 | 83 kg/m3 |
| 10 | 188 kg/m3 | 182 kg/m3 | 78 kg/m3 | 75 kg/m3 |
| Stitch Size | Cotton | Cotton/Linen | Polyacrylonitrile | PAN/Wool |
|---|---|---|---|---|
| 2 | - | - | 9.4 mm | 9.9 mm |
| 4 | - | 11.3 mm | 11.2 mm | 11.3 mm |
| 6 | 12.7 mm | 12.5 mm | 12.7 mm | 12.5 mm |
| 8 | 14.2 mm | 14.8 mm | 14.8 mm | 14.2 mm |
| 10 | 17.5 mm | 16.6 mm | 17.0 mm | 15.7 mm |
| Stitch Size | Cotton | Cotton/Linen | Polyacrylonitrile | PAN/Wool |
|---|---|---|---|---|
| 2 | - | - | 6.1/cm | 6.0/cm |
| 4 | - | 6.4/cm | 4.9/cm | 5.7/cm |
| 6 | 5.1/cm | 5.5/cm | 4.0/cm | 5.0/cm |
| 8 | 4.3/cm | 4.8/cm | 3.3/cm | 4.1/cm |
| 10 | 4.0/cm | 4.0/cm | 2.7/cm | 3.6/cm |
| Stitch Size | Cotton | Cotton/Linen | Polyacrylonitrile | PAN/Wool |
|---|---|---|---|---|
| 2 | - | - | 4.7/cm | 5.1/cm |
| 4 | - | 3.8/cm | 4.5/cm | 4.6/cm |
| 6 | 4.0/cm | 3.2/cm | 4.3/cm | 3.7/cm |
| 8 | 3.6/cm | 2.9/cm | 4.0/cm | 3.3/cm |
| 10 | 2.9/cm | 2.4/cm | 3.7/cm | 2.8/cm |
© 2019 by the authors. Licensee MDPI, Basel, Switzerland. This article is an open access article distributed under the terms and conditions of the Creative Commons Attribution (CC BY) license (http://creativecommons.org/licenses/by/4.0/).
Share and Cite
Helberg, J.; Klöcker, M.; Sabantina, L.; Storck, J.L.; Böttjer, R.; Brockhagen, B.; Kinzel, F.; Rattenholl, A.; Ehrmann, A. Growth of Pleurotus Ostreatus on Different Textile Materials for Vertical Farming. Materials 2019, 12, 2270. https://doi.org/10.3390/ma12142270
Helberg J, Klöcker M, Sabantina L, Storck JL, Böttjer R, Brockhagen B, Kinzel F, Rattenholl A, Ehrmann A. Growth of Pleurotus Ostreatus on Different Textile Materials for Vertical Farming. Materials. 2019; 12(14):2270. https://doi.org/10.3390/ma12142270
Chicago/Turabian StyleHelberg, Julia, Michaela Klöcker, Lilia Sabantina, Jan Lukas Storck, Robin Böttjer, Bennet Brockhagen, Franziska Kinzel, Anke Rattenholl, and Andrea Ehrmann. 2019. "Growth of Pleurotus Ostreatus on Different Textile Materials for Vertical Farming" Materials 12, no. 14: 2270. https://doi.org/10.3390/ma12142270
APA StyleHelberg, J., Klöcker, M., Sabantina, L., Storck, J. L., Böttjer, R., Brockhagen, B., Kinzel, F., Rattenholl, A., & Ehrmann, A. (2019). Growth of Pleurotus Ostreatus on Different Textile Materials for Vertical Farming. Materials, 12(14), 2270. https://doi.org/10.3390/ma12142270

